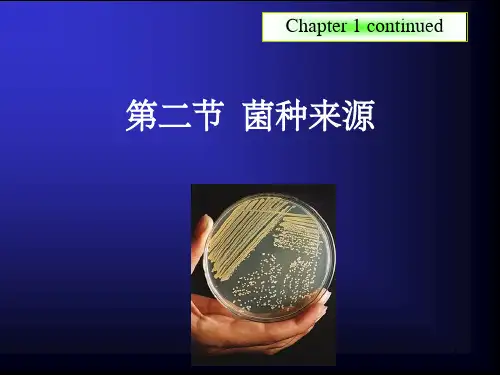

第二章生产菌种的来源
- 格式:pdf
- 大小:3.45 MB
- 文档页数:36

微生物工程试卷题型分配:名词解释: 15题共45分简答题: 7题共35分论述题: 2题共20分第一章概论1.微生物工程:即是指发酵工程,指采用现代工程技术手段,利用微生物的某些特定功能,为人类生产有用的产品,或直接把微生物应用于工业生产过程的一种技术.2.简述微生物工程发展简史(四个阶段特征):天然发酵,纯培养技术,深层培养技术,微生物工程.3.简述微生物工程组成及研究内容:从广义上讲,由三部分组成:上游工程,发酵工程,下游工程。
微生物工程研究内容:无菌生长技术,计算机控制技术,种子培养和生产培养工艺技术,小试中试动力学模型,发酵工程工艺放大。
第二章生产菌种的来源1.试述生产菌种的来源及其分离思路来源:根据资料直接向科研单位、高等院校、工厂或菌种保藏部门索取或购买;从大自然中分离筛选新的微生物菌种。
分离思路:依照生产要求、产物性质、菌种特性(分类地位及生态环境),设计各种筛选方法,快速、准确地把所需要的菌种挑选出来2.试述生物物质产生菌的分离纯化和筛选步骤定方案:查阅资料,了解所需菌种的生长培养特性。
标本采集:有针对性地采集样品增殖:人为地通过控制养分或培条件,使所需菌种增殖培养后,在数量上占优势。
分离:利用分离技术得到纯种。
性能鉴定发酵性能测定:进行生产性能测定。
这些特性包括形态、培养特征、营养要求、生理生化特性、发酵周期、产品品种和产量、耐受最高温度、生长和发酵最适温度、最适 pH值、提取工艺等。
第三章微生物代谢调节及代谢工程1.新陈代谢(分解代谢、合成代谢):是指发生在活细胞中的各种分解代谢和合成代谢的总和。
分解代谢:指复杂的有机物分子通过分解代谢酶系的催化,产生简单分子、腺苷三磷酸(ATP)形式的能量和还原力(或称还原当量,一般用[H]来表示)的作用。
合成代谢:与分解代谢正好相反,是指在合成代谢酶系的催化下,由简单小分子、ATP形式的能量和[H]形式的还原力一起合成复杂大分子的过程。
2.酶活性调节:酶分子水平上的一种代谢调节,通过改变酶分子活性来调节新陈代谢的速率,包括:酶活性的激活和抑制两个方面。

第一部分:微生物工程原理1、概论1.1 发酵工程的概念和特点1.2 发酵工业的发展简史1.3 发酵工程的应用2、生产菌种来源3、微生物代谢调节和代谢工程4、优良菌种选育5、菌种保藏6、培养基7、发酵工艺控制8、参数检测第二部分:微生物工程下游加工工程第三部分:微生物工程生产设备第四部分:微生物工程生产工艺和产品举例第一章概论掌握本章知识点:1、发酵及发酵工程的定义;2、发酵工程研究的内容;3、发酵技术的发展阶段及其技术特点;4、发酵产物类型。
1、发酵、发酵工程的概念和特点1)传统发酵:最初发酵是用来描述酵母菌作用于果汁或麦芽汁产生气泡的现象,或者是指酒的生产过程。
2)生化和生理学意义的发酵:指微生物在无氧条件下,分解各种有机物质产生能量的一种方式,或者更严格地说,发酵是以有机物作为电子受体的氧化还原产能反应。
巴斯德:发酵是酵母菌在无氧状态下的呼吸过程,即无氧呼吸,是“生物获得能量的一种方式”。
3)工业上:泛指利用微生物制造或生产某些产品的过程。
包括:厌氧培养的生产过程,如酒精,乳酸等。
通气(有氧)培养的生产过程,如抗生素、氨基酸、酶制剂等。
4)发酵工程:利用微生物的生长代谢活动来生产各种有用生物化学产品的技术过程。
5)发酵工程研究的内容①一条主线:菌种,培养基,种子扩大培养,发酵过程控制,后处理;②两个重点:发酵过程优化,发酵过程放大;③三个层次:反应器水平,细胞水平,分子水平;④四个目标:高转化,高产量,高效率,低成本;6)利用发酵工程进行生产的优点:安全生产,可持续发展。
7)发酵过程存在的问题和缺陷:发酵过程会产生副产物;菌种易发生变异和退化;发酵过程的控制相当复杂;原料主要是农副产品,质量和价格波动较大;与化工过程相比,反应器的效率低;发酵废水量大,并含较高的COD和BOD;;生产过程易受杂菌污染的影响。
8)上游工程:菌种培养发酵工程:发酵罐下游工程:产物提纯2、发酵工业的发展简史1)古老的发酵工业-1900年前(白酒酿造;面包发酵、奶酪制造;酱油、泡菜)特点:多菌混合天然发酵2)早期的发酵工业1900-1940(酒精,乳酸)1680 荷兰列文虎克观察到微生物。